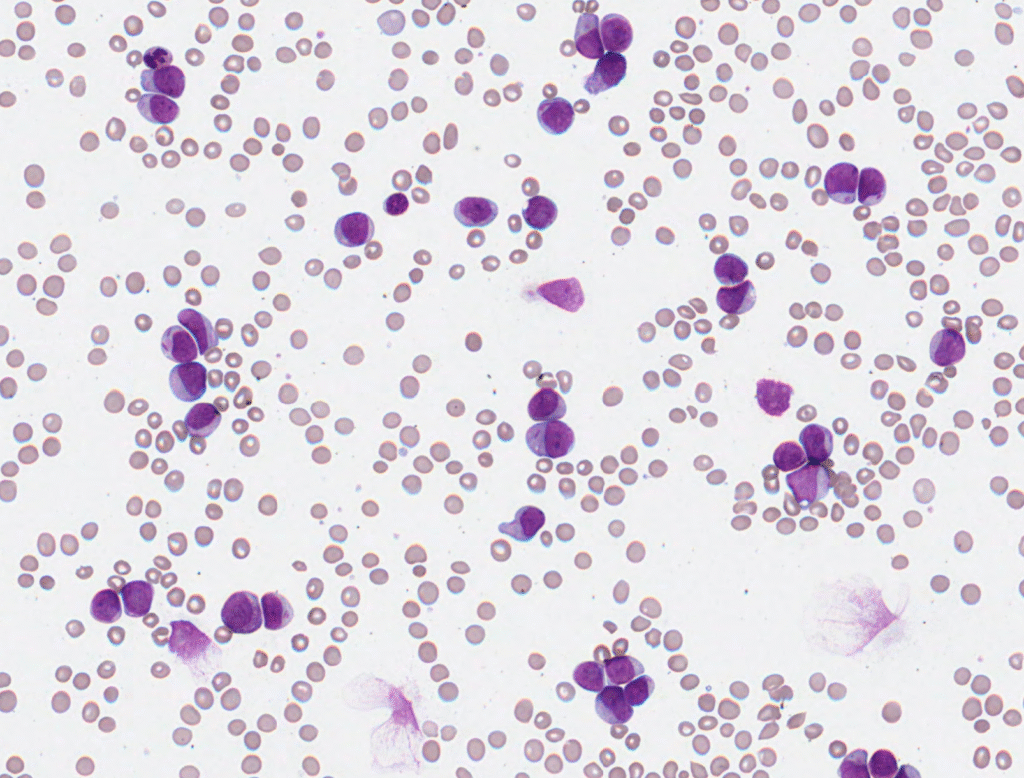

This week’s Morphology Monday case featured a 59-year-old male who presented to the Emergency Department with increasing fatigue, shortness of breath, and spontaneous bruising.
Laboratory investigations showed a WBC of 168 × 10⁹/L, raising immediate concern for a leukaemic process.

The blood film showed numerous myeloid blasts with Auer rods, supporting the diagnosis of AML. Flow cytometry revealed a blast population accounting for 88.7% of total cells, with a myeloid immunophenotype (CD34–, CD45+, CD117+, HLA-DR–, CD13+, CD15–, CD16–, CD33+, CD64+, CD71+, CD123+, CD38+). The absence of lymphoid markers (CD7–, CD19–) and the presence of myeloid antigens supported a diagnosis of myeloid lineage involvement.
Molecular testing confirmed NPM1 mutation and FLT3 internal tandem duplication (ITD), with no evidence of t(8;21) or inv(16). These findings are characteristic of acute myeloid leukaemia (AML) with NPM1 mutation and FLT3-ITD, a subtype associated with distinct prognostic implications.
Together, the morphology, immunophenotype, and molecular profile confirmed acute myeloid leukaemia (AML).